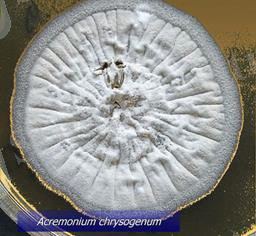
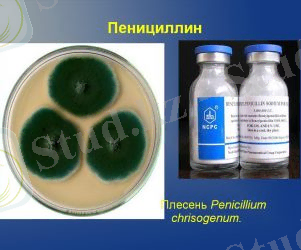

Антибиотик түзетін микроорганизмдер: шығу көздері, актиномицеттер және өндіріс тәсілдері


ҚАЗАҚСТАН РЕСПУБЛИКАСЫНЫҢ БІЛІМ ЖӘНЕ ҒЫЛЫМ МИНСТРЛІГІ
ҚАЗАҚ ҰЛТТЫҚ АГРАРЛЫҚ ЗЕРТТЕУ УНИВЕРСИТЕТІ

РЕФЕРАТ
Тақырыбы: «Антибиотик түзуші микроорганизмдер»
Қабылдаған: Қожахметова З. А
Орындаған:Шайхидинова О
Тобы:БТ-204
Жоспар:
1. Кіріспе
1. 1. Антибиотиктерге сипаттама
1. 2. Микроорганизмдерге қысқаша сипаттама
2. Негізгі бөлім
2. 1 Антибиотиктердің алыну көздері
2. 2 Актиномицеттер - антибиотиктер продуценттері
2. 3 Микроорганизмдерден алынатын антибиотиктер
3. Қорытынды
Пайдаланылған әдебиеттер
1. 1 Антибиотиктер (гр. autі - қарсы және гр. bіos - тіршілік) - микроорганизмдердің өсуін, көбеюін тежейтін немесе тоқтататын микробтар, өсімдіктер мен жануарлар жасушасынан алынатын органикалық зат; микроорганизмдермен жоғары өсімдіктермен және жануарлармен микроорганизмдерді және ісік жасушаларының дамуын басатын және жоятын заттар. Антибиотиктер микробтар мен кейбір қатерлі ісікке әсер етіп, олардың дамуын тежейді немесе жойып жібереді. Антибиотиктердің пайда болуы микробтар дүниесінде кездесетін бір-біріне қарама-қарсылық әрекетіне негізделген. Бірінші антибиотикті 1929 ж. ағылшын бактериологы А. Флеминг ашты. Ол көгергіш саңырауқұлағы Пенициллиум контатумды зерттеу кезінде бактериялық культураның өвуіне кедергі жасайтын затты анықтап, оны пенициллин деп атады. А. Флеминг алғашқы антибиотикті ашқаннан кейінгі 60 жыл ішінде 6000-ға жуық антибиотиктер алынды, сондықтан қазір ең маңызды мәселелердің бірі осы препараттарды жүйелеу болып отыр. Антибиотиктердің әртүрлі жіктелуі бар, бірақ оның ешқайсысы жалпы қабылданған емес. 1940 ж. Г. Флори және Э. Чейн пенициллинді алды. 1945 ж. А. Флеминг, Г. Флори және Э. Чейн Нобель лауреаты атағын алды. Антибиотиктердің бірнеше жүздеген түрі бар, бірақ олардың бәрі бірдей меди цинада қолданыла бермейді. Антибиотиктер шығу тегі, химиялық құрамы, микробтарға әсер ету механизмі т. б. қасиеттері бойынша жіктеледі. Антибиотиктерді ретсіз қолданудың әртүрлі салдары болуы мүмкін. Мысалы, денеге бөртпе шығып, қышыма пайда болады, кейде естен тануға әкеп соғады. Сондықтан оларды тек қана дәрігердің айтуы бойынша қолдану қажет. Антибиотиктер медицинадан басқа ауыл шаруашылығында, тамақ өнеркәсібінде және микробиологиялық өндірісте пайдаланылады. Антибиотиктер зен саңырауқұлаңынан, актиномиоцидтік, кейбір бактериялардан алынады. Антибиотиктердің көпшілігін биосинтездеу арқылы алады. Онда актиномицеттер, саңырауқұлақтар және бактериялардың микроорганизмдері қолданылады. Бағалы антибиотиктердің көпшілігі актиномицет культурасынан алынады. Актиномицеттер (ескі атауы: сәулелі саңырауқұлақтар) - диаметрі 0, 4-1, 5 мкм-ге дейін жететін даму сатыларының кейбір стадияларында бұтақтанған мицелий құруға қабілеті бар бактериялар (кейбір ғалымдар актиномицеттердің бактериалды табиғатына байланысты саңырауқұлақтық мицелий аналогы - жіңішке жіпшелер деп атайды) тобы. Ең кең таралған жері - топырақ: оның құрамында актиномицеттердің барлық туыс өкілдері кездеседі. Люминесцентті микроскопия көмегімен анықталатын прокариотты биомассаның 10-15% мөлшерін және дәстүрлі қоректік орталарда сұйытылған топырақ суспензиясын егу кезінде өсіп шығатын бактериялардың ¼ бөлігін құрайды.
1. 2 Микроорганизмдер - тек қана микроскоппен көруге болатын өте ұсақ организмдер. Олардың клеткалары миллиметтердің мыңнан бір бөлігімен өлшенеді. Микроорганикалық құрылысын, сыртқы пішінін және қозғалысын зерттеу үшін кем дегенде 100 есе үлкейтіп көрсететін арнаулы құрал - микроскоптар қолданылуда. Микроорганизмдердің ішкі құрылысын зерттеуге арналған, ол-1 есе, кейде жүз мың есе үлкейте алатын электронды микроскоптар да бар. Бұл микроскопта зерттеу үшін, клетканы алдын-ала түрлі бояу заттары флуорхромдармен бояйды. Мұндай боялған микроорганизмдер тірі күйінде люминесценттік микроскопта сәуле шашып, жалтырап көрінеді де, зерттеу оңайлайды. Микроорганизмдер бір ортада топталып тіршілік етсе, онда колониялар түзеді. Кейде осы колонияның пішініне, сыртқы түріне, түсіне қарап, ол микроорганизмнің қай топқа жататынын анықтауға болады. Бұларды алғаш рет 17 ғасырда голланд ғалымы А. В. Левенгук ашқан. Микроорганизмдер арасында прокариоттар және эукариоттар тобына жататындары бар. Кейде Микроорганизмдерге вирустарды да жатқызады. Микроорганизмдер мөлшері жағынан тым ұсақ болғандықтан, оларды табиғи субстраттардан оқшаулап алуда (таза дақыл күйінде), өсіруде және зерттеуде ерекше тәсілдерді қолдауды қажет етеді. Микроорганизмдерді зерттейтін ғылым саласы - микробиология. Микроорганизмдердің басым көпшілігі бір клеткалы организмдер. Олар, көбінесе, қарапайым бөліну арқылы тез көбейеді. Табиғаттағы тірі организмдер мейлінше алуан түрлі болады. Олардың ішінде өсімдіктер мен жануарлар дүниесінен басқа, жай көзге көрінбейтін тірі организмдер - микроорганизмдер елеулі орын алады. Кейбіреулері ауыл шаруашылығында, медицинада баға жетпес пайда келтірсе, басқа біреулері жануарлар мен өсімдіктерге және адамдарға орасан зор зиянын тигізеді. Микроорганизмдердің практикалық маңызы зор. Олардың көпшілігі өнеркәсіптің әр түрлі саласында (мал азықтық белокты түзу, шарап жасау, нан пісіру, сүт қышқылы тағамдарын өндіру кезінде антибиотиктер, витаминдер, амин қышқылдары, кейбір ферменттер, т. б. ), адам шауашылығында (сүрлем даярлауда, өсімдіктерді биологиялық жолмен қорғауда) кеңінен қолданылады. Сондай-ақ Микроорганизмдер лас суларды тазартуда, жанар газ - метанды түзуде пайдаланылады. Бірқатар Микроорганизмдер адамдар, жануарлар және өсімдіктердің патогені болып саналады. Микроорганизмдердің кейбір түрлері топырақты құнарсыздандырып, көптеген адам шауашылығын өнімдерін бүлдіреді, металдардың коррозияға ұшырауына ықпал етеді. Микроорганизмдер биологияның көптеген мәселелерін шешуде маңызды зерттеу нысаны болып саналады. Соның нәтижесінде көптеген биологиялық заңдылықтар ашылып, биотехнологияның негізі қаланды.
2. 1 А. Флеминг алғашқы антибиотикті ашқаннан кейінгі 60 жыл ішінде 6000-ға жуық антибиотиктер алынды.
Алыну көзіне байланысты антибиотиктерді 5 топқа ажыратады:
- Саңырауқұлақтардан алынатын антибиотиктер, мысалы: Пенициллиум (пеницил, гризеофульвин), Цефалоспориум (цефалоспорин), Фузидиум (фузидин) және т. б.
- Актиномициттерден алынатын антибиотиктер, бұл топқа антибиотиктердің 80% енеді. Антибиотиктердің арасында ең негізгі стрептомицин, эритромицин, левомицетин, нистатин және басқа антибиотиктерді өндіретін стрептомицес өкілдері.
- Бактериялардан алынатын антибиотиктер. Бұл мақсатта жиі қолданылатын Бациллиус және Pseudomonos өкілдері. Бұл топқа мысал ретінде полимиксинді айтуға болады.
- Жануарлардан алынатын антибиотиктер. Балықтың майынан эктерицидті алады.
- Өсімдіктерден алынатын антибиотиктер. Оларға пияздан, сарымсақтан, басқа өсімдіктерден алынатын фитонцидтерді жатқызуға болады. Олар өте тұрақсыз қосылыстар болғандықтан таза күйінде алынбаған. Көртеген микробтардың антимикробтық қасиеті бар. Мысалы, ромашка, шалфей, календула.
Антибиотиктерді алудың 3 тәсілі бар:
Биологиялық синтез
Бұл тәсілмен антибиотиктерді алу үшін, микроорганизмдердің жоғарғы өнімді штаммдарын және оларды өсіретін арнайы қоректік орталарын пайдаланады. Мысалы, бұл тәсілмен пенициллинді алады.
Химиялық синтез
Кейбір антибиотиктердің құрылымын білгеннен кейін, оларды химиялық синтездеу тәсілімен алу мүмкіндігі туды. Мысалы, бұл тәсілмен алынған алғашқы антибиотктердің алғашқысы - левомицетин.
Комбинирленген тәсіл.
Бұл тәсіл алдыңғы екі тәсілдің ұштасуы болып табылады. Биологиялық синтез жолыменантибиотиктің ядросые алса (мысалы, пенициллен в-аминопенициллан қышқылын) ал, химиялық синтез жолымен оған әр түрлі радикалдарды қосады. Осы тәсілмен алынған антибиотиктерді жартылай синтетикалық деп атайды. Мысалы: жартылай синтетикалық цефалоспорин, тетрациклин антибиотиктерді кеңінен қолданыс тапқан. Жартылай синтетикалық антибиотиктердің ерекшелігі олардың табиғи антибиотиктерге тұрақты микроорганизмдердің сезімталдылығы болып табылады. Бұл әдіс антибиотиктер өндірісінде кең қолданылады.
Саңырауқұлақтарда бағалы антибиотиктер продуцентінің тобына Fungi imperfecti кіреді. Актиномицеттер мен бактериялар сияқты, саңырауқұлақтар табиғатта кең таралған. Агарлы ортада өсіргенде бірінші колонна түзіледі. Субстраттан тұратын ауа мицелиясы және қоздырғышқа эффективті қатынасы мынадай антибиотиктен (макролид, новобицин, ванкомицин, ристоцетин, циклосерин, канамицин) тұрады. Бұл препараттардың әрқайсысы өндірісте пиницилин мен стрептомицинге жетпейді. Бірақ жалпы препараттың шығуы әлемге танымал. Антибиотиктер өндірісі қысқа мерзім ішінде ғалымдар мен өндіріс жұмысшыларын бірігуімен ашылды. Соңғы жылдары үлкен зауыттар салынды. Олар үлкен масштабта және жоғарғы сапада антибиотик заттарын шығара бастады. Жалпы антибиотик өндірісінің көлемі жағынан әлемде біздің еліміз екінші орын алады. Кейбір препараттар клиникалық тексергенде жақсы деп табылды.
2. 2
Практикада кең қолданысқа ие антибиотиктер актиномицеттердің метаболиттері болып саналады. Актиномицетті шығу тегіне ие ең бірінші антибиотиктердің бірі мицетин, ол 1939 жылы совет ғалымдары Красильников және Коренякомен ашылды. 1940 жылы актиномицетин (Вельш, 1937) және
 мицетин, сонымен қатар, пенициллин деген антибиотикалық заттар анықталды. Актиномицеттердің денесі саңырауқұлақтарға ұқсас, тармақталған жіпшелерден - мицелийлерден тұрады. Кейбір актиномицеттердің мицелийлері бөлінген кезде таяқша тəрізді жəне сферикалық бактерияларға ұқсас клеткаларға бөлінеді. Актиномицеттер грам оң, клеткалары қозғалмайды, көбі түсіне байланысты əр түрлі пигменттер түзеді жəне спорамен немесе жай бөліну арқылы көбейеді. Кейбір актиномицеттердің мицелийлерінің ұшында бірнеше спорасы бар спороносецтер пайда болады. Топырақта тіршілік ететін актиномицеттердің көпшілігі клеткаларының пішіні мен түстеріне, спороносецтерінің құрылысына жəне антибиотиктерді түзуіне байланысты бірнеше топқа бөлінде. Жоғарғы сатылы актиномицеттердің көбісінің антибиотик продуценті ретінде маңызы зор. Актиномицеттер қатары бұл қатарға бір клеткалы проактиномицеттер және актиномицеттер деп аталатын екі тұқымдас жатады. Бірінші тұқымдасқа таяқша тәрізді, бұтақтануға бейім бактериялар жатады. Олардың бір ерекшелігі-бұтақталған бір клеткалы мицелий түрінде өсуі. Оның бір ұшы ортаға бекиді де, екінші ұшы ауада қалады. Бұлар ауадағы мицелий ұшында пайда болатын споралар арқылы көбейеді. Актиномицеттер табиғатта кең тараған, олар топырақта, суда және өсімдіктер мен жануарлар қалдықтарында тіршілік етеді. Сөйтіп топырақтағы органикалық қалдықтарды ыдыратын, гумус, яғни қарашірікті тузуге қатысыды. Актиномицеттер өз денесінен ортаға түрлі түсті бояулар (пигменттер) бөледі. Кейбір түрлері адам мен жануарлар болатын актиномикоз деп аталатын қауіпті ауруды қоздырады. Актиномицеттердің өніп-өсуіне ең қолайлы температура +23-27° жылылық Құрғақшылыққа төзімді, кейде құрғақ топырақта он жылдан астам уақытқа дейін тіршілігін сақтай алады. Көптеген актиномицеттер адамдар мен жанурларда, өсімдіктерде кездесетін бактериялар мен вирустардың ауруларымен күресуге аса қажетті антибиотик заттарын бөліп шығарады. Ол заттар медицинада, ветеринарияда кеңінен қолданылып отыр. Микроорганизмдердің актиномицеттер өндіретін 4000 астам антибиотиктер анықталған. Әрбір антибиотик тек ауру қоздырғыш микроорганизмдердің белгілі бір тобына ғана жойқын әсер етеді. Актиномицеттер витаминдер, гормондар, ферменттер, токсиндер, өсу заттары, аминоқышқылдар және адам үшін қажетті басқа да биологиялық белсенді заттар түзуге қабілетті. Топырақ құнарлылығын қалыптастыру және топырақ шығару прцесстеріне актиномицеттер белсенді түрде қатысады. Оларға топырақты қалпына келтіруді жүзеге асыратын көптеген функцияларды жатқызады. Ең алғаш болып актиномицеттерді 1878 жылы Ц. Гарц анықтаған болатын. 1945 жылы С. Ваксман және А. Шатц актиномицеттер дақылдарынан медицинада кең қолданыс тапқан
стрептомицин
антибиотигін бөліп алды. Стрептомицин - аминогликозидтер тобына жататын, әсер ету ауқымы кең антибиотик. Сәулелі саңырауқұлақтардың Streptomyces globisporus немесе басқа да Streptomyces spp. түрлерінің тіршілігі барысында түзіледі. Төмен концентрацияларда бактериостатикалық әсер береді: микроб жасушасының ішіне еніп, рибосоманың 30S суббірлігінде спецификалық ақуыз-рецепторлармен байланысып, бұған түрткі болатын «рибосомның матрицалық РНҚ-30S суббірлігі» кешенінің түзілуін бұзады, бұл нәтижесінде микроб жасушаларының өсуі мен дамуының тоқтауына әкеледі. Жоғарырақ концентрацияларда стрептомицин бактерицидтік әсер береді (цитоплазмалық жарғақшаларды зақымдап, микроб жасушаларын істен шығарады. Микробтарға қарсы әсер ету ауқымы кең. Mycobacterium tuberculosis, көптеген грамтеріс бактерияларға Francisella tularensis, Haemophilus ducreyi, Haemophilus influenzae, Neisseria gonorrhoeae, Neisseria meningitidis, кейбір грамоң микроорганизмдерге (Staphylococcus spp., Corynebacterium diphtheriae) қатысты белсенді. Streptococcus spp. (соның ішінде Streptococcus pneumoniae), Enterococcus spp. қатысты орташа белсенді. Әлсізқышқыл ортада тұрақты, бірақ қыздырған кезде қышқылдар мен сілтілердің ерітінділерінде оңай ыдырайды. Бактериялардың екінші қайтара тұрақтылығы тез дамиды. Стрептомицин анаэробтық бактерияларға, Spirochaetaceae, Rickettsia spp., Pseudomonas aeruginosa тектестеріне қатысты белсенеді емес.
мицетин, сонымен қатар, пенициллин деген антибиотикалық заттар анықталды. Актиномицеттердің денесі саңырауқұлақтарға ұқсас, тармақталған жіпшелерден - мицелийлерден тұрады. Кейбір актиномицеттердің мицелийлері бөлінген кезде таяқша тəрізді жəне сферикалық бактерияларға ұқсас клеткаларға бөлінеді. Актиномицеттер грам оң, клеткалары қозғалмайды, көбі түсіне байланысты əр түрлі пигменттер түзеді жəне спорамен немесе жай бөліну арқылы көбейеді. Кейбір актиномицеттердің мицелийлерінің ұшында бірнеше спорасы бар спороносецтер пайда болады. Топырақта тіршілік ететін актиномицеттердің көпшілігі клеткаларының пішіні мен түстеріне, спороносецтерінің құрылысына жəне антибиотиктерді түзуіне байланысты бірнеше топқа бөлінде. Жоғарғы сатылы актиномицеттердің көбісінің антибиотик продуценті ретінде маңызы зор. Актиномицеттер қатары бұл қатарға бір клеткалы проактиномицеттер және актиномицеттер деп аталатын екі тұқымдас жатады. Бірінші тұқымдасқа таяқша тәрізді, бұтақтануға бейім бактериялар жатады. Олардың бір ерекшелігі-бұтақталған бір клеткалы мицелий түрінде өсуі. Оның бір ұшы ортаға бекиді де, екінші ұшы ауада қалады. Бұлар ауадағы мицелий ұшында пайда болатын споралар арқылы көбейеді. Актиномицеттер табиғатта кең тараған, олар топырақта, суда және өсімдіктер мен жануарлар қалдықтарында тіршілік етеді. Сөйтіп топырақтағы органикалық қалдықтарды ыдыратын, гумус, яғни қарашірікті тузуге қатысыды. Актиномицеттер өз денесінен ортаға түрлі түсті бояулар (пигменттер) бөледі. Кейбір түрлері адам мен жануарлар болатын актиномикоз деп аталатын қауіпті ауруды қоздырады. Актиномицеттердің өніп-өсуіне ең қолайлы температура +23-27° жылылық Құрғақшылыққа төзімді, кейде құрғақ топырақта он жылдан астам уақытқа дейін тіршілігін сақтай алады. Көптеген актиномицеттер адамдар мен жанурларда, өсімдіктерде кездесетін бактериялар мен вирустардың ауруларымен күресуге аса қажетті антибиотик заттарын бөліп шығарады. Ол заттар медицинада, ветеринарияда кеңінен қолданылып отыр. Микроорганизмдердің актиномицеттер өндіретін 4000 астам антибиотиктер анықталған. Әрбір антибиотик тек ауру қоздырғыш микроорганизмдердің белгілі бір тобына ғана жойқын әсер етеді. Актиномицеттер витаминдер, гормондар, ферменттер, токсиндер, өсу заттары, аминоқышқылдар және адам үшін қажетті басқа да биологиялық белсенді заттар түзуге қабілетті. Топырақ құнарлылығын қалыптастыру және топырақ шығару прцесстеріне актиномицеттер белсенді түрде қатысады. Оларға топырақты қалпына келтіруді жүзеге асыратын көптеген функцияларды жатқызады. Ең алғаш болып актиномицеттерді 1878 жылы Ц. Гарц анықтаған болатын. 1945 жылы С. Ваксман және А. Шатц актиномицеттер дақылдарынан медицинада кең қолданыс тапқан
стрептомицин
антибиотигін бөліп алды. Стрептомицин - аминогликозидтер тобына жататын, әсер ету ауқымы кең антибиотик. Сәулелі саңырауқұлақтардың Streptomyces globisporus немесе басқа да Streptomyces spp. түрлерінің тіршілігі барысында түзіледі. Төмен концентрацияларда бактериостатикалық әсер береді: микроб жасушасының ішіне еніп, рибосоманың 30S суббірлігінде спецификалық ақуыз-рецепторлармен байланысып, бұған түрткі болатын «рибосомның матрицалық РНҚ-30S суббірлігі» кешенінің түзілуін бұзады, бұл нәтижесінде микроб жасушаларының өсуі мен дамуының тоқтауына әкеледі. Жоғарырақ концентрацияларда стрептомицин бактерицидтік әсер береді (цитоплазмалық жарғақшаларды зақымдап, микроб жасушаларын істен шығарады. Микробтарға қарсы әсер ету ауқымы кең. Mycobacterium tuberculosis, көптеген грамтеріс бактерияларға Francisella tularensis, Haemophilus ducreyi, Haemophilus influenzae, Neisseria gonorrhoeae, Neisseria meningitidis, кейбір грамоң микроорганизмдерге (Staphylococcus spp., Corynebacterium diphtheriae) қатысты белсенді. Streptococcus spp. (соның ішінде Streptococcus pneumoniae), Enterococcus spp. қатысты орташа белсенді. Әлсізқышқыл ортада тұрақты, бірақ қыздырған кезде қышқылдар мен сілтілердің ерітінділерінде оңай ыдырайды. Бактериялардың екінші қайтара тұрақтылығы тез дамиды. Стрептомицин анаэробтық бактерияларға, Spirochaetaceae, Rickettsia spp., Pseudomonas aeruginosa тектестеріне қатысты белсенеді емес.
2. 3 Пенициллиндер (Penicillium chrysogenum, P. notatum) және цефалоспориндер мицеллалы саңырауқұлақтар өндіретін аса белгілі бета-лактамды антибиотиктердің өкілдері. Олардың сипатында антимикробты әсеріне қабілетті бета-лактамды сақина құрылымы кездесуі. Бұл грам теріс микроорганизмдер тудырған инфекцияда қолданатын антибиотиктер клетка қабырғасының пептидогликан синтезін тежейді. Клиникалық практикада бета-лактамды топтың модификациясы немесе пенициллинді басқа антимикробты заттармен қосу арқылы дайындалғанжартылай синтетикалық пенициллин туындылары жиі қолданылады.

- Іс жүргізу
- Автоматтандыру, Техника
- Алғашқы әскери дайындық
- Астрономия
- Ауыл шаруашылығы
- Банк ісі
- Бизнесті бағалау
- Биология
- Бухгалтерлік іс
- Валеология
- Ветеринария
- География
- Геология, Геофизика, Геодезия
- Дін
- Ет, сүт, шарап өнімдері
- Жалпы тарих
- Жер кадастрі, Жылжымайтын мүлік
- Журналистика
- Информатика
- Кеден ісі
- Маркетинг
- Математика, Геометрия
- Медицина
- Мемлекеттік басқару
- Менеджмент
- Мұнай, Газ
- Мұрағат ісі
- Мәдениеттану
- ОБЖ (Основы безопасности жизнедеятельности)
- Педагогика
- Полиграфия
- Психология
- Салық
- Саясаттану
- Сақтандыру
- Сертификаттау, стандарттау
- Социология, Демография
- Спорт
- Статистика
- Тілтану, Филология
- Тарихи тұлғалар
- Тау-кен ісі
- Транспорт
- Туризм
- Физика
- Философия
- Халықаралық қатынастар
- Химия
- Экология, Қоршаған ортаны қорғау
- Экономика
- Экономикалық география
- Электротехника
- Қазақстан тарихы
- Қаржы
- Құрылыс
- Құқық, Криминалистика
- Әдебиет
- Өнер, музыка
- Өнеркәсіп, Өндіріс
Қазақ тілінде жазылған рефераттар, курстық жұмыстар, дипломдық жұмыстар бойынша біздің қор #1 болып табылады.



Ақпарат
Қосымша
Email: info@stud.kz